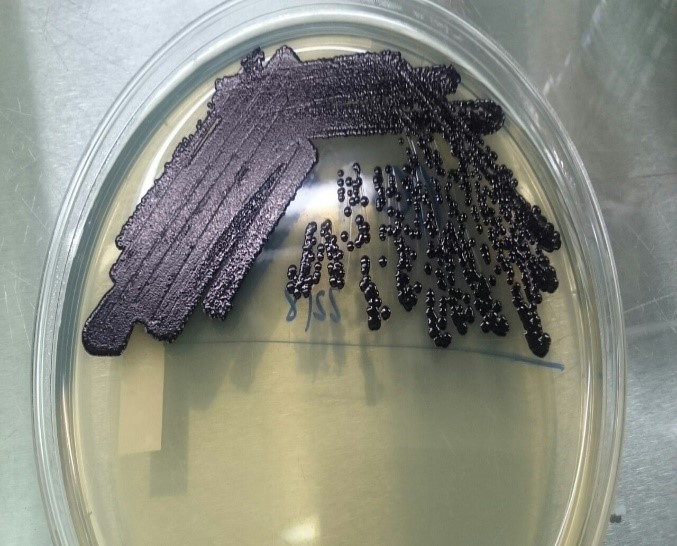

Nhiễm trùng là sự xâm nhập của các vi sinh vật (vi khuẩn, vi rút, nấm hoặc ký sinh trùng,…) vào trong cơ thể và gây ra các phản ứng tế bào, tổ chức hoặc phản ứng toàn thân (nhiễm khuẩn, nhiễm độc). Vi sinh vật xâm nhập vào trong cơ thể vật chủ qua da, niêm mạc, các vị trí tổn thương, theo đường máu lan tràn trong cơ thể.
Các triệu chứng biểu hiện trên lâm sàng thể hiện một số hội chứng nhiễm khuẩn, nhiễm độc. Tuy nhiên có một số vi sinh vật tự nhiên sống trong cơ thể không được coi là nhiễm trùng (như vi khuẩn thường trú trong ruột và miệng, …vi khuẩn trong đường tiêu hóa (lợi khuẩn) còn có thể giúp chúng ta tiêu hóa thức ăn). Có rất nhiều căn nguyên gây nhiễm trùng, để phân biệt nhiễm trùng do vi khuẩn, vi rút, nấm hay ký sinh trùng là rất quan trọng cho việc chẩn đoán và điều trị bệnh. Mỗi loại nhiễm trùng do các căn nguyên khác nhau thì sẽ có phác đồ điều trị khác nhau (như nhiễm trùng do vi khuẩn thường điều trị bằng kháng sinh, nhiễm trùng do nấm thì điều trị bằng thuốc kháng nấm,…).
Phân loại nhiễm trùng theo vị trí giải phẫu của cơ quan bị nhiễm bệnh như: nhiễm trùng máu (nhiễm khuẩn huyết), nhiễm trùng đường tiết niệu, nhiễm trùng da, nhiễm trùng đường hô hấp, nhiễm trùng âm đạo, nhiễm trùng ối, nhiễm trùng vết mổ,…
Bệnh có thể gây hậu quả nghiêm trọng như phát triển thành dịch (dịch tả do vi khuẩn Vibrio cholerae, dịch bạch hầu do vi khuẩn Corynebacterium diphtheriae, não mô cầu do vi khuẩn Neisseria meningitidis,…), bệnh uốn ván (vi khuẩn Clostridium tetani), ngộ độc thực phẩm (vi khuẩn E. coli, Salmonella, Shigella, …), gây tiêu chảy, viêm ruột kết (vi khuẩn Clostridium difficile) nhiễm trùng tiết niệu, viêm mô bào (vi khuẩn Staphylococcus aureus,…), ngộ độc thịt (vi khuẩn Clostridium botulinum), bệnh viêm âm đạo do nấm (nấm Candida sp), nhiễm khuẩn huyết dẫn đến hoại tử các cơ quan (vi khuẩn Bukholderia pseudomallei, …), kéo dài thời gian nằm viện điều trị, thậm trí dẫn đến tử vong. Việc tiến hành xét nghiệm nuôi cấy, định danh vi sinh vật là rất cần thiết để phát hiện sớm bệnh do căn nguyên nào, từ đó kịp thời làm kháng sinh đồ phù hợp để xác định mức độ nhạy cảm của vi sinh vật để đưa ra phác đồ điều trị hiệu quả đem lại ý nghĩa quan trọng trong công tác chẩn đoán nhanh, góp phần vào công tác phòng chống dịch bệnh và nâng cao chất lượng khám chữa bệnh, giúp người bệnh giảm thiểu chi phí điều trị và nhanh khỏi bệnh.
Các xét nghiệm dùng trong chẩn đoán, tiên lượng và điều trị bao gồm nuôi cấy, xác định vi sinh vật bằng phương pháp thông thường, bằng hệ thống máy Vitek 2 compact, hệ thống máy Phonex, hệ thống Maldi biotyper (Malditof). Trong đó xác định vi sinh vật bằng hệ thống định danh nhanh Maldi biotyper là phương pháp nhanh nhất và hiệu quả nhất. Dữ liệu chủng vi sinh vật từ hệ thống Malditof được quản lý và cập nhật thường xuyên từ ngân hàng vi sinh vật thế giới, với cơ sở dữ liệu của hơn 8000 loài vi sinh vật khác nhau.
1. Xét nghiệm nuôi cấy, xác định vi sinh vật bằng hệ thống Maldi biotyper
Nuôi cấy, phân lập và xác định vi sinh vật là kỹ thuật vô cùng quan trọng trong chẩn đoán vi sinh vật, nhằm xác định nguyên nhân gây bệnh có trong mẫu bệnh phẩm.
Nguyên lý định danh bằng hệ thống Malditof: Định danh vi sinh vật bằng dấu ấn sinh học phân tử MALDI Biotyper hay định danh vi sinh vật bằng kỹ thuật khối phổ MALDI-TOF (Matrix-Assisted Laser Desorption Ionization/Time of Flight) là để xác định dấu ấn protein duy nhất của mỗi vi sinh vật. Mẫu phổ đặc trưng của dấu ấn protein dùng để định danh chính xác và tin cậy một loại vi sinh vật cụ thể bằng cách kết hợp hàng nghìn phổ tham chiếu từ các chủng vi sinh vật.
Chỉ cần một vài bước đơn giản đã có thể định danh được vi sinh vật ở mức cao và đáng tin cậy. Quá trình thu thập khối phổ và so sánh với khối phổ đã được chuẩn hóa làm cho việc định danh vi sinh vật có độ chính xác cao trong mỗi lần chạy. Việc theo dõi toàn bộ quá trình chạy được thực hiện nhờ sử dụng barcode trên đĩa MALDI đảm bảo không phân tích sai. Thông thường chỉ cần không nhiều hơn một khuẩn lạc từ đĩa nuôi cấy hoặc một phần nhỏ từ môi trường canh thang là có thể xác định được căn nguyên. Toàn bộ quá trình định danh chỉ mất khoảng vài phút và ít hơn một giờ cho 96 mẫu và cho kết quả nhanh hơn 24h so với các phương pháp truyền thống khác. Sau khi có dữ liệu phổ và phổ phù hợp thì hệ thống sẽ cho ra một báo cáo tổng quan với kết quả định danh cho từng mẫu.


2. Ý nghĩa của việc xác định vi sinh vật bằng hệ thống Maldi biotyper
Với mục tiêu điều trị là tiêu diệt vi sinh vật gây bệnh trong cơ thể bệnh nhân và tình trạng vi khuẩn kháng kháng sinh ngày càng gia tăng thì xác định đúng vi sinh vật để dùng đung thuốc cho từng loại vi sinh vật là rất cần thiết nhằm giảm thiểu vi khuẩn đa kháng và bệnh nhân có kháng sinh điều trị.
Quy trình làm việc của MALDI Biotyper nhanh chóng, đơn giản và dễ thực hiện. Việc định danh vi sinh vật thì nhanh, nhạy, chính xác, và kết quả rất dễ giải thích.
Tiết kiệm thời gian định danh giảm đáng kể, kết quả xét nghiệm nuôi cấy được trả sớm nhất (24h-48h nuôi cấy).
Chi phí cho mỗi xét nghiệm thấp hơn nhiều so với các phương pháp sinh hóa và phân tử truyền thống.
Định danh được cả vi khuẩn hiếu kỵ khí tùy tiện, nấm men, nấm sợi, và các vi khuẩn kỵ khí bắt buộc mà các phương pháp thông thường không định danh được, ngoài ra có thể định danh vi sinh vật trực tiếp từ chai cấy máu dương với thể tích sử dụng 1ml.
3. Quy trình xác định vi sinh vật bằng hệ thống Maldi biotyper
– Mẫu bệnh phẩm được nuôi cấy vào các môi trường thích hợp sau 18 – 24h, nếu có vi sinh vật mọc:
– Ghi sơ đồ mẫu;
– Nhỏ 1 μL dung dịch BTS vào một vị trí của đĩa MALDI target;
– Phết mỗi mẫu khuẩn lạc thuần lên một vị trí (spot) của đĩa MALDI target;

– Lưu ý chỉ phết một lượng nhỏ khuẩn lạc (vừa đủ nhìn thấy), có thể sử dụng tăm tiệt trùng (toothpicks) để phết;
– Để mẫu khô ở nhiệt độ phòng;
– Cho 1 μL dung dịch acid formic để khô ở nhiệt độ phòng với trường hợp định danh nấm hoặc các vi khuẩn có vỏ dày, có sinh nha bào;
– Cho 1 μL dung dịch HCCA Matrix lên mỗi vị trí mẫu;

– Để khô ở nhiệt độ phòng (5 – 20 phút);
– Khởi động hệ thống

– Đưa đĩa MALDI Target vào máy MALDI Biotyper để thực hiện định danh;

– Phiên giải kết quả
– Trả kết quả: Với những kết quả có giá trị ở mức độ tin cậy cao, trả tên vi sinh vật đến cấp độ loài.
Việc sử dụng hệ thống định danh MALDI Biotyper từ năm 2012 tại Bệnh viện đến nay đã giúp Bác sĩ điều trị cho Bệnh nhân giảm đáng kể thời gian nằm viện, sử dụng thuốc đúng phác đồ dẫn đến tận dụng đáng kể nguồn tài nguyên, giảm thiểu nguy cơ tử vong.
ThS. Nguyễn Thị Tươi, Khoa Vi sinh – sinh học phân tử , Bệnh viện Bệnh Nhiệt đới Trung ương